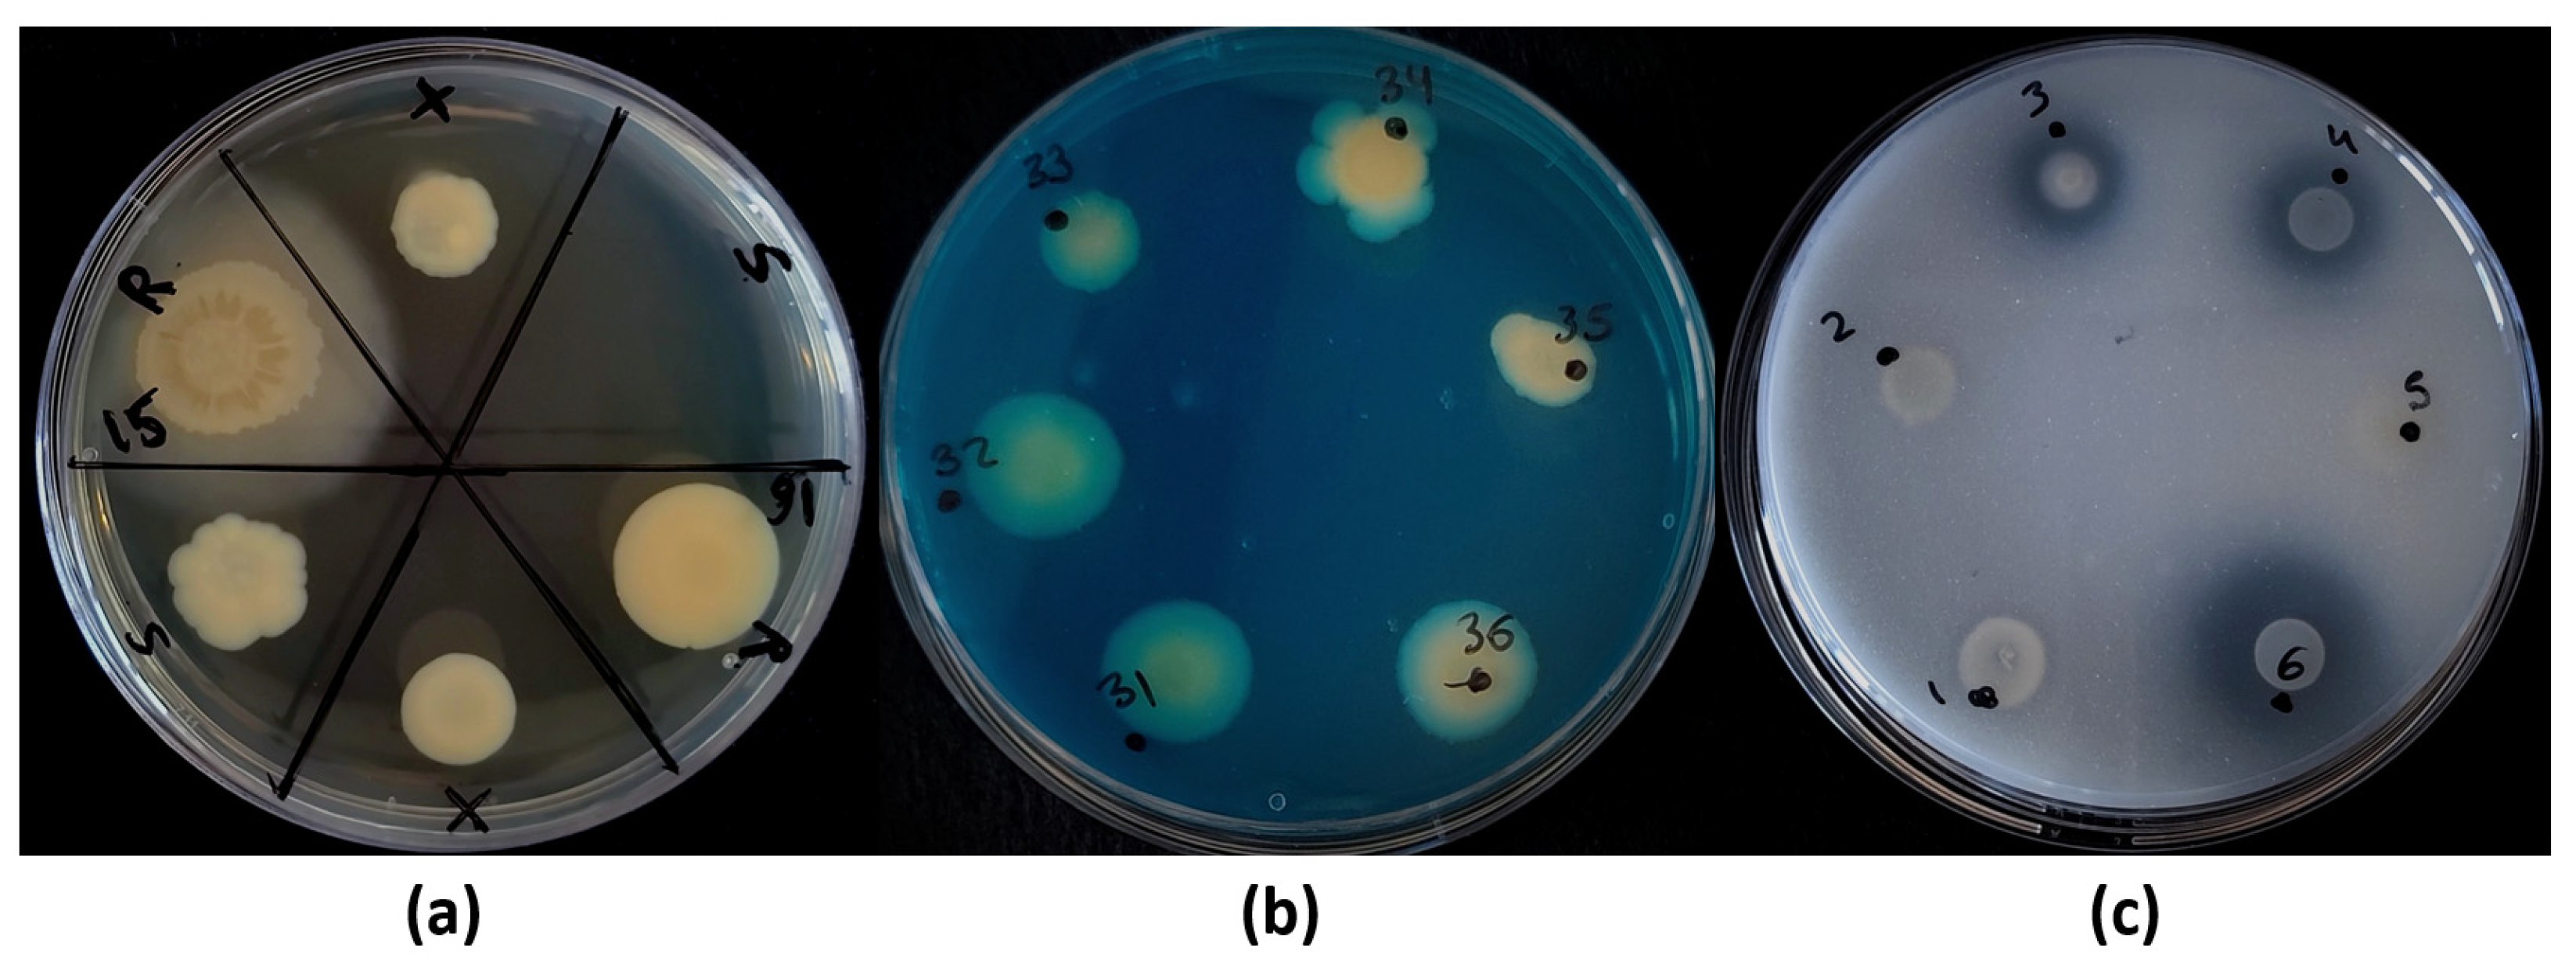
Biology 11 01838 g006 Biology 11 01838 g006

Geographically Disperse, Culturable Seed-Associated Microbiota in Forage Plants of Alfalfa (Medicago sativa L.) and Pitch Clover (Bituminaria bituminosa L.): Characterization of Beneficial Inherited Strains as Plant Stress-Tolerance Enhancers
Abstract
Simple Summary
Abstract
1. Introduction
2. Materials and Methods
2.1. Sampling Process
2.2. Germination Process
2.3. Culturable Bacteria Isolation, Identification and Collection Storage
Phylogenetical Trees and Venn Diagrams: Analysis of Culturable Populations
2.4. Plant-Growth-Promotion and Stress-Tolerance-Enhancing Skills
2.4.1. Drought Survival Mechanism: Xerotolerance vs. Sporulation
2.4.2. Biofilm Production
2.4.3. Auxin Production
2.4.4. Aminocyclopropane-1-Carboxylic Acid (ACC) Deaminase Production
2.4.5. Siderophore Production
2.4.6. Phosphate Solubilization
2.5. Plant Inoculation: Growth Promotion and Drought Tolerance Enhancement
2.6. Statistics
3. Results
3.1. Soil Characterization: pH, Electroconductivity and Water Content
3.2. Germination Rate
3.3. Characterization of the Strains: Identification, Population Distribution and Comparative Analysis
3.4. Screening for Plant-Growth-Promoting and Drought-Tolerance-Enhancement Skills
3.4.1. Main Stress-Survival Mechanism
3.4.2. Biofilm, Auxins and ACC Deaminase Production
3.4.3. Siderophore Production and Phosphate Solubilization
3.5. Plant Inoculation: Plant-Growth Promotion and Drought-Tolerance Enhancement
4. Discussion
5. Conclusions
Supplementary Materials
Author Contributions
Funding
Institutional Review Board Statement
Informed Consent Statement
Data Availability Statement
Acknowledgments
Conflicts of Interest
References
- Rising, J.; Devineni, N. Crop switching reduces agricultural losses from climate change in the United States by half under RCP 8.5. Nat. Commun. 2020, 11, 4991. [Google Scholar] [CrossRef] [PubMed]
- Sulser, T.; Wiebe, K.D.; Dunston, S.; Cenacchi, N.; Nin-Pratt, A.; Mason-D’Croz, D.; Robertson, R.D.; Willenbockel, D.; Rosegrant, M.W. Climate Change and Hunger: Estimating Costs of Adaptation in the Agrifood System; International Food Policy Research Institute: Washington, DC, USA, 2021. [Google Scholar]
- Nelson, G.C.; Rosegrant, M.W.; Koo, J.; Robertson, R.D.; Sulser, T.; Zhu, T.; Ringler, C.; Msangi, S.; Palazzo, A.; Batka, M.; et al. Climate Change: Impact on Agriculture and Costs of Adaptation; International Food Policy Research Institute: Washington, DC, USA, 2009. [Google Scholar]
- Cramer, W.; Guiot, J.; Fader, M.; Garrabou, J.; Gattuso, J.-P.; Iglesias, A.; Lange, M.A.; Lionello, P.; Llasat, M.C.; Paz, S.; et al. Climate change and interconnected risks to sustainable development in the Mediterranean. Nat. Clim. Chang. 2018, 8, 972–980. [Google Scholar] [CrossRef]
- Lange, M.A. Impacts of climate change on the Eastern Mediterranean and the Middle East and North Africa Region and the water–energy nexus. Atmosphere 2019, 10, 455. [Google Scholar] [CrossRef]
- Ahluwalia, O.; Singh, P.C.; Bhatia, R. A review on drought stress in plants: Implications, mitigation and the role of plant growth promoting rhizobacteria. Resour. Environ. Sustain. 2021, 5, 100032. [Google Scholar] [CrossRef]
- Ullah, A.; Bano, A.; Khan, N. Climate change and salinity effects on crops and chemical communication between plants and plant growth-promoting microorganisms under stress. Front. Sustain. Food Syst. 2021, 5, 618092. [Google Scholar] [CrossRef]
- Ferreira, H.; Pinto, E.; Vasconcelos, M.W. Legumes as a cornerstone of the transition toward more sustainable agri-food systems and diets in Europe. Front. Sustain. Food Syst. 2021, 5, 694121. [Google Scholar] [CrossRef]
- Semba, R.D.; Ramsing, R.; Rahman, N.; Kraemer, K.; Bloem, M.W. Legumes as a sustainable source of protein in human diets. Glob. Food Secur. 2021, 28, 100520. [Google Scholar] [CrossRef]
- Fulkerson, W.J.; Neal, J.S.; Clark, C.F.; Horadagoda, A.; Nandra, K.S.; Barchia, I. Nutritive value of forage species grown in the warm temperate climate of Australia for dairy cows: Grasses and legumes. Livest. Sci. 2007, 107, 253–264. [Google Scholar] [CrossRef]
- Daryanto, S.; Wang, L.; Jacinthe, P.A. Global synthesis of drought effects on food legume production. PLoS ONE 2015, 10, e0127401. [Google Scholar] [CrossRef]
- Khatun, M.; Sarkar, S.; Era, F.M.; Islam, A.K.M.M.; Anwar, M.P.; Fahad, S.; Datta, R.; Islam, A.K.M.A. Drought stress in grain legumes: Effects, tolerance mechanisms and management. Agronomy 2021, 11, 2374. [Google Scholar] [CrossRef]
- Kunert, K.J.; Vorster, B.J.; Fenta, B.A.; Kibido, T.; Dionisio, G.; Foyer, C.H. Drought stress responses in soybean roots and nodules. Front. Plant Sci. 2016, 7, 1015. [Google Scholar] [CrossRef] [PubMed]
- Nadeem, M.; Li, J.; Yahya, M.; Sher, A.; Ma, C.; Wang, X.; Qiu, L. Research progress and perspective on drought stress in legumes: A review. Int. J. Mol. Sci. 2019, 20, 2541. [Google Scholar] [CrossRef] [PubMed]
- Singh, S.; Kudapa, H.; Garg, V.; Varshney, R.K. Comprehensive analysis and identification of drought-responsive candidate NAC genes in three semi-arid tropics (SAT) legume crops. BMC Genom. 2021, 22, 289. [Google Scholar] [CrossRef]
- Dovrat, G.; Masci, T.; Bakhshian, H.; Mayzlish Gati, E.; Golan, S.; Sheffer, E. Drought-adapted plants dramatically downregulate dinitrogen fixation: Evidences from Mediterranean legume shrubs. J. Ecol. 2018, 106, 1534–1544. [Google Scholar] [CrossRef]
- Whitehead, S.R.; Turcotte, M.M.; Poveda, K. Domestication impacts on plant-herbivore interactions: A meta-analysis. Philos. Trans. R. Soc. Lond. B Biol. Sci. 2017, 372, 20160034. [Google Scholar] [CrossRef] [PubMed]
- Fernandez, A.R.; Sáez, A.; Quintero, C.; Gleiser, G.; Aizen, M.A. Intentional and unintentional selection during plant domestication: Herbivore damage, plant defensive traits and nutritional quality of fruit and seed crops. New Phytol. 2021, 231, 1586–1598. [Google Scholar] [CrossRef] [PubMed]
- Singh, J.; van der Knaap, E. Unintended consequences of plant domestication. Plant Cell Physiol. 2022, 63, 1573–1583. [Google Scholar] [CrossRef] [PubMed]
- Soldan, R.; Fusi, M.; Cardinale, M.; Daffonchio, D.; Preston, G.M. The effect of plant domestication on host control of the microbiota. Commun. Biol. 2021, 4, 936. [Google Scholar] [CrossRef]
- Gutierrez, A.; Grillo, M.A. Effects of domestication on plant-microbiome interactions. Plant Cell Physiol. 2022, 63, 1654–1666. [Google Scholar] [CrossRef]
- Abdullaeva, Y.; Ratering, S.; Ambika Manirajan, B.; Rosado-Porto, D.; Schnell, S.; Cardinale, M. Domestication impacts the wheat-associated microbiota and the rhizosphere colonization by seed- and soil-originated microbiomes, across different fields. Front. Plant Sci. 2022, 12, 806915. [Google Scholar] [CrossRef]
- Pérez-Jaramillo, J.E.; Mendes, R.; Raaijmakers, J.M. Impact of plant domestication on rhizosphere microbiome assembly and functions. Plant Mol. Biol. 2016, 90, 635–644. [Google Scholar] [CrossRef] [PubMed]
- Gaete, A.; Pulgar, R.; Hodar, C.; Maldonado, J.; Pavez, L.; Zamorano, D.; Pastenes, C.; González, M.; Franck, N.; Mandakovic, D. Tomato cultivars with variable tolerances to water deficit differentially modulate the composition and interaction patterns of their rhizosphere microbial communities. Front. Plant Sci. 2021, 12, 688533. [Google Scholar] [CrossRef] [PubMed]
- Carrillo, J.; Ingwell, L.L.; Li, X.; Kaplan, I. Domesticated tomatoes are more vulnerable to negative plant–soil feedbacks than their wild relatives. J. Ecol. 2019, 107, 1753–1766. [Google Scholar] [CrossRef]
- Smulders, L.; Benítez, E.; Moreno, B.; López-García, Á.; Pozo, M.J.; Ferrero, V.; de la Peña, E.; Alcalá Herrera, R. Tomato domestication affects potential functional molecular pathways of root-associated soil bacteria. Plants 2021, 10, 1942. [Google Scholar] [CrossRef] [PubMed]
- Riley, A.B.; Grillo, M.A.; Epstein, B.; Tiffin, P.; Heath, K.D. Discordant population structure among rhizobium divided genomes and their legume hosts. Mol. Ecol. 2022. [Google Scholar] [CrossRef]
- Iannucci, A.; Fragasso, M.; Beleggia, R.; Nigro, F.; Papa, R. Evolution of the crop rhizosphere: Impact of domestication on root exudates in tetraploid wheat (Triticum turgidum L.). Front. Plant Sci. 2017, 8, 2124. [Google Scholar] [CrossRef]
- Martínez-Romero, E.; Aguirre-Noyola, J.L.; Taco-Taype, N.; Martínez-Romero, J.; Zuñiga-Dávila, D. Plant microbiota modified by plant domestication. Syst. Appl. Microbiol. 2020, 43, 126106. [Google Scholar] [CrossRef]
- Hwang, Y.; Schulze-Makuch, D.; Arens, F.L.; Saenz, J.S.; Adam, P.S.; Sager, C.; Bornemann, T.L.V.; Zhao, W.; Zhang, Y.; Airo, A.; et al. Leave no stone unturned: Individually adapted xerotolerant Thaumarchaeota sheltered below the boulders of the Atacama Desert hyperarid core. Microbiome 2021, 9, 234. [Google Scholar] [CrossRef]
- López, M.C.; Galán, B.; Carmona, M.; Navarro Llorens, J.M.; Peretó, J.; Porcar, M.; Getino, L.; Olivera, E.R.; Luengo, J.M.; Castro, L.; et al. Xerotolerance: A new property in Exiguobacterium genus. Microorganisms 2021, 9, 2455. [Google Scholar] [CrossRef]
- Poudel, M.; Mendes, R.; Costa, L.A.S.; Bueno, C.G.; Meng, Y.; Folimonova, S.Y.; Garrett, K.A.; Martins, S.J. The role of plant-associated bacteria, fungi, and viruses in drought stress mitigation. Front. Microbiol. 2021, 12, 743512. [Google Scholar] [CrossRef]
- Gamalero, E.; Glick, B.R. Recent advances in bacterial amelioration of plant drought and salt stress. Biology 2022, 11, 437. [Google Scholar] [CrossRef] [PubMed]
- Mapelli, F.; Riva, V.; Vergani, L.; Choukrallah, R.; Borin, S. Unveiling the microbiota diversity of the xerophyte Argania spinosa L. skeels root system and residuesphere. Microb. Ecol. 2020, 80, 822–836. [Google Scholar] [CrossRef] [PubMed]
- Lebre, P.H.; De Maayer, P.; Cowan, D.A. Xerotolerant bacteria: Surviving through a dry spell. Nat. Rev. Microbiol. 2017, 15, 285–296. [Google Scholar] [CrossRef]
- Bonatelli, M.L.; Lacerda-Júnior, G.V.; dos Reis Junior, F.B.; Fernandes-Júnior, P.I.; Melo, I.S.; Quecine, M.C. Beneficial plant-associated microorganisms from semiarid regions and seasonally dry environments: A review. Front. Microbiol. 2021, 11, 553223. [Google Scholar] [CrossRef] [PubMed]
- Ayangbenro, A.S.; Babalola, O.O. Reclamation of arid and semi-arid soils: The role of plant growth-promoting archaea and bacteria. Curr. Plant Biol. 2021, 25, 100173. [Google Scholar] [CrossRef]
- Nelson, E.B. The seed microbiome: Origins, interactions, and impacts. Plant Soil 2018, 422, 7–34. [Google Scholar] [CrossRef]
- Wang, M.; Eyre, A.W.; Thon, M.R.; Oh, Y.; Dean, R.A. Dynamic changes in the microbiome of rice during shoot and root growth derived from seeds. Front. Microbiol. 2020, 11, 559728. [Google Scholar] [CrossRef]
- Wagner, M.R.; Busby, P.E.; Balint-Kurti, P. Analysis of leaf microbiome composition of near-isogenic maize lines differing in broad-spectrum disease resistance. New Phytol. 2020, 225, 2152–2165. [Google Scholar] [CrossRef]
- Abdelfattah, A.; Wisniewski, M.; Schena, L.; Tack, A.J.M. Experimental evidence of microbial inheritance in plants and transmission routes from seed to phyllosphere and root. Environ. Microbiol. 2021, 23, 2199–2214. [Google Scholar] [CrossRef]
- Rodríguez, C.E.; Antonielli, L.; Mitter, B.; Trognitz, F.; Sessitsch, A. Heritability and functional importance of the Setaria viridis bacterial seed microbiome. Phytobiomes J. 2020, 4, 40–52. [Google Scholar] [CrossRef]
- Mitter, B.; Pfaffenbichler, N.; Flavell, R.; Compant, S.; Antonielli, L.; Petric, A.; Berninger, T.; Naveed, M.; Sheibani-Tezerji, R.; von Maltzahn, G.; et al. A new approach to modify plant microbiomes and traits by introducing beneficial bacteria at flowering into progeny seeds. Front. Microbiol. 2017, 8, 11. [Google Scholar] [CrossRef] [PubMed]
- Hone, H.; Mann, R.; Yang, G.; Kaur, J.; Tannenbaum, I.; Li, T.; Spangenberg, G.; Sawbridge, T. Profiling, isolation and characterisation of beneficial microbes from the seed microbiomes of drought tolerant wheat. Sci. Rep. 2021, 11, 11916. [Google Scholar] [CrossRef] [PubMed]
- Mahmood, A.; Turgay, O.C.; Farooq, M.; Hayat, R. Seed biopriming with plant growth promoting rhizobacteria: A review. FEMS Microbiol. Ecol. 2016, 92, fiw112. [Google Scholar] [CrossRef] [PubMed]
- Shahzad, R.; Khan, A.L.; Bilal, S.; Asaf, S.; Lee, I.-J. What is there in seeds? Vertically transmitted endophytic resources for sustainable improvement in plant growth. Front. Plant Sci. 2018, 9, 24. [Google Scholar] [CrossRef] [PubMed]
- Compant, S.; Cambon, M.C.; Vacher, C.; Mitter, B.; Samad, A.; Sessitsch, A. The plant endosphere world—Bacterial life within plants. Environ. Microbiol. 2021, 23, 1812–1829. [Google Scholar] [CrossRef] [PubMed]
- Simonin, M.; Briand, M.; Chesneau, G.; Rochefort, A.; Marais, C.; Sarniguet, A.; Barret, M. Seed microbiota revealed by a large-scale meta-analysis including 50 plant species. New Phytol. 2022, 234, 1448–1463. [Google Scholar] [CrossRef] [PubMed]
- Noori, F.; Etesami, H.; Noori, S.; Forouzan, E.; Salehi Jouzani, G.; Malboobi, M.A. Whole genome sequence of Pantoea agglomerans ANP8, a salinity and drought stress-resistant bacterium isolated from alfalfa (Medicago sativa L.) root nodules. Biotechnol. Rep. 2021, 29, e00600. [Google Scholar] [CrossRef]
- Noori, F.; Etesami, H.; Najafi Zarini, H.; Khoshkholgh-Sima, N.A.; Hosseini Salekdeh, G.; Alishahi, F. Mining alfalfa (Medicago sativa L.) nodules for salinity tolerant non-rhizobial bacteria to improve growth of alfalfa under salinity stress. Ecotoxicol. Environ. Saf. 2018, 162, 129–138. [Google Scholar] [CrossRef]
- Issah, G.; Schoenau, J.J.; Lardner, H.A.; Knight, J.D. Nitrogen fixation and resource partitioning in alfalfa (Medicago sativa L.), cicer milkvetch (Astragalus cicer L.) and sainfoin (Onobrychis viciifolia Scop.) using 15N enrichment under controlled environment conditions. Agronomy 2020, 10, 1438. [Google Scholar] [CrossRef]
- Martínez-Fernández, D. Physiological responses of Bituminaria bituminosa to drought and heavy metals. J. Plant Physiol. 2012, 168, 2206–2211. [Google Scholar] [CrossRef]
- Foster, K.; Ryan, M.; Real, D.; Ramankutty, P.; Lambers, H. Drought resistance at the seedling stage in the promising fodder plant tedera (Bituminaria bituminosa var. albomarginata). Crop Pasture Sci. 2012, 63, 1034–1042. [Google Scholar] [CrossRef]
- Real, D.; Li, G.D.; Clark, S.; Albertsen, T.O.; Hayes, R.C.; Denton, M.D.; Antuono, M.F.; Dear, B.S. Evaluation of perennial forage legumes and herbs in six Mediterranean environments. Chil. J. Agric. Res. 2011, 71, 357–369. [Google Scholar] [CrossRef][Green Version]
- do Rosário, L. Indicadores de Desertificaçao para Portugal Continental; Direcção-Geral dos Recursos Florestais: Lisboa, Portugal, 2004.
- Serrano, L.R. Managing desertification in a national context. In Desertification in Europe: Mitigation Strategies, Land Use Planning; Enne, C., Zanolla, C., Peter, D., Eds.; European Communities: Luxembourg, 2000. [Google Scholar]
- Mclean, E.O. Soil pH and lime requirement. In Methods of Soil Analysis, Part 2: Chemical and Microbiological Properties; Page, A.L., Ed.; American Society of Agronomy, Inc.: Madison, WI, USA, 1983; pp. 199–224. [Google Scholar]
- Li, H.; Wang, W. Determination and analysis of phreatic water evaporation in extra-arid dune region. Acta Ecol. Sin. 2014, 34, 116–122. [Google Scholar] [CrossRef]
- del Barrio, G.; Puigdefabregas, J.; Sanjuan, M.E.; Stellmes, M.; Ruiz, A. Assessment and monitoring of land condition in the Iberian Peninsula, 1989–2000. Remote Sens. Environ. 2010, 114, 1817–1832. [Google Scholar] [CrossRef]
- Vílchez, J.I.; Yang, Y.; Yi, D.; Zhang, H. Measurements of root colonized bacteria species. Bio-Protocol 2021, 11, e3976. [Google Scholar] [CrossRef]
- Breakwell, D.; Woolverton, C.; MacDonald, B.; Smith, K.; Robison, R. Colony morphology protocol. In Proceedings of the 14th American Society for Microbiology Conference for Undergraduate Educators (ASMCUE), Buffalo, NY, USA, 29 September 2007. [Google Scholar]
- Dashti, A.; Jadaon, M.; Abdulsamad, A.; Dashti, H. Heat treatment of bacteria: A simple method of DNA extraction for molecular techniques. Kuwait Med. J. 2009, 41, 117–122. [Google Scholar]
- Letunic, I.; Bork, P. Interactive Tree Of Life (iTOL) v5: An online tool for phylogenetic tree display and annotation. Nucleic Acids Res. 2021, 49, W293–W296. [Google Scholar] [CrossRef] [PubMed]
- Heberle, H.; Meirelles, G.V.; da Silva, F.R.; Telles, G.P.; Minghim, R. InteractiVenn: A web-based tool for the analysis of sets through Venn diagrams. BMC Bioinform. 2015, 16, 169. [Google Scholar] [CrossRef]
- Wu, X.; Monchy, S.; Taghavi, S.; Zhu, W.; Ramos, J.; van der Lelie, D. Comparative genomics and functional analysis of niche-specific adaptation in Pseudomonas putida. FEMS Microbiol. Rev. 2011, 35, 299–323. [Google Scholar] [CrossRef]
- Narváez-Reinaldo, J.J.; Barba, I.; González-López, J.; Tunnacliffe, A.; Manzanera, M. Rapid method for isolation of desiccation-tolerant strains and xeroprotectants. Appl. Environ. Microbiol. 2010, 76, 5254–5262. [Google Scholar] [CrossRef]
- Coffey, B.M.; Anderson, G.G. Biofilm formation in the 96-well microtiter plate. Methods Mol. Biol. 2014, 1149, 631–641. [Google Scholar] [CrossRef] [PubMed]
- Louden, B.C.; Haarmann, D.; Lynne, A.M. Use of blue agar CAS assay for siderophore detection. J. Microbiol. Biol. Educ. 2011, 12, 51–53. [Google Scholar] [CrossRef] [PubMed]
- Nautiyal, C.S. An efficient microbiological growth medium for screening phosphate solubilizing microorganisms. FEMS Microbiol. Lett. 1999, 170, 265–270. [Google Scholar] [CrossRef] [PubMed]
- Shahzad, Z.; Kellermeier, F.; Armstrong, E.M.; Rogers, S.; Lobet, G.; Amtmann, A.; Hills, A. EZ-Root-VIS: A Software pipeline for the rapid analysis and visual reconstruction of root system architecture. Plant Physiol. 2018, 177, 1368–1381. [Google Scholar] [CrossRef]
- Johnston-Monje, D.; Raizada, M.N. Conservation and diversity of seed associated endophytes in Zea across boundaries of evolution, ethnography and ecology. PLoS ONE 2011, 6, e20396. [Google Scholar] [CrossRef]
- Krawczyk, K.; Borodynko-Filas, N. Kosakonia cowanii as the new bacterial pathogen affecting soybean (Glycine max Willd.). Eur. J. Plant Pathol. 2020, 157, 173–183. [Google Scholar] [CrossRef]
- Kado, C. Erwinia and related genera. In The Prokaryotes; Springer: New York, NY, USA, 2006; Volume 6, pp. 443–450. [Google Scholar]
- Díaz Herrera, S.; Grossi, C.; Zawoznik, M.; Groppa, M.D. Wheat seeds harbour bacterial endophytes with potential as plant growth promoters and biocontrol agents of Fusarium graminearum. Microbiol. Res. 2016, 186–187, 37–43. [Google Scholar] [CrossRef]
- Bziuk, N.; Maccario, L.; Straube, B.; Wehner, G.; Sørensen, S.J.; Schikora, A.; Smalla, K. The treasure inside barley seeds: Microbial diversity and plant beneficial bacteria. Environ. Microbiome 2021, 16, 20. [Google Scholar] [CrossRef]
- Langendries, S.; Goormachtig, S. Paenibacillus polymyxa, a Jack of all trades. Environ. Microbiol. 2021, 23, 5659–5669. [Google Scholar] [CrossRef]
- Grady, E.N.; MacDonald, J.; Liu, L.; Richman, A.; Yuan, Z.-C. Current knowledge and perspectives of Paenibacillus: A review. Microb. Cell Factories 2016, 15, 203. [Google Scholar] [CrossRef]
- Dolkar, D.; Dolkar, P.; Angmo, S.; Chaurasia, O.P.; Stobdan, T. Stress tolerance and plant growth promotion potential of Enterobacter ludwigii PS1 isolated from seabuckthorn rhizosphere. Biocatal. Agric. Biotechnol. 2018, 14, 438–443. [Google Scholar] [CrossRef]
- Tsotetsi, T.; Nephali, L.; Malebe, M.; Tugizimana, F. Bacillus for plant growth promotion and stress resilience: What have we learned? Plants 2022, 11, 2482. [Google Scholar] [CrossRef] [PubMed]
- Alexander, A.; Singh, V.K.; Mishra, A. Halotolerant PGPR Stenotrophomonas maltophilia BJ01 induces salt tolerance by modulating physiology and biochemical activities of Arachis hypogaea. Front. Microbiol. 2020, 11, 568289. [Google Scholar] [CrossRef] [PubMed]
- Singh, R.P.; Jha, P.N. The PGPR Stenotrophomonas maltophilia SBP-9 Augments resistance against biotic and abiotic stress in wheat plants. Front. Microbiol. 2017, 8, 1945. [Google Scholar] [CrossRef]
- Timmusk, S.; Grantcharova, N.; Wagner, E.G. Paenibacillus polymyxa invades plant roots and forms biofilms. Appl. Environ. Microbiol. 2005, 71, 7292–7300. [Google Scholar] [CrossRef]
- Timmusk, S.; Wagner, E.G.H. The plant-growth-promoting rhizobacterium Paenibacillus polymyxa induces changes in Arabidopsis thaliana gene expression: A possible connection between biotic and abiotic stress responses. Mol. Plant-Microbe Interact. 1999, 12, 951–959. [Google Scholar] [CrossRef]
- Trinh, C.S.; Jeong, C.Y.; Lee, W.J.; Truong, H.A.; Chung, N.; Han, J.; Hong, S.-W.; Lee, H. Paenibacillus pabuli strain P7S promotes plant growth and induces anthocyanin accumulation in Arabidopsis thaliana. Plant Physiol. Biochem. 2018, 129, 264–272. [Google Scholar] [CrossRef]
- Ou, T.; Zhang, M.; Huang, Y.; Wang, L.; Wang, F.; Wang, R.; Liu, X.; Zhou, Z.; Xie, J.; Xiang, Z. Role of rhizospheric Bacillus megaterium HGS7 in maintaining mulberry growth under extremely abiotic stress in hydro-fluctuation belt of three gorges reservoir. Front. Plant Sci. 2022, 13, 880125. [Google Scholar] [CrossRef]
- Luziatelli, F.; Gatti, L.; Ficca, A.G.; Medori, G.; Silvestri, C.; Melini, F.; Muleo, R.; Ruzzi, M. Metabolites secreted by a plant-growth-promoting Pantoea agglomerans strain improved rooting of Pyrus communis L. cv dar gazi cuttings. Front. Microbiol. 2020, 11, 539359. [Google Scholar] [CrossRef]
- Khan, M.A.; Asaf, S.; Khan, A.L.; Jan, R.; Kang, S.-M.; Kim, K.-M.; Lee, I.-J. Thermotolerance effect of plant growth-promoting Bacillus cereus SA1 on soybean during heat stress. BMC Microbiol. 2020, 20, 175. [Google Scholar] [CrossRef]
- Girsowicz, R.; Moroenyane, I.; Steinberger, Y. Bacterial seed endophyte community of annual plants modulated by plant photosynthetic pathways. Microbiol. Res. 2019, 223–225, 58–62. [Google Scholar] [CrossRef]
- Seo, M.-S.; Song, H.-G. Growth promotion of tomato plant under drought conditions by treatment of rhizobacteria producing ACC deaminase and phytohormones. Korean J. Microbiol. 2013, 49, 46–50. [Google Scholar] [CrossRef]
- Ranawat, B.; Bachani, P.; Singh, A.; Mishra, S. Enterobacter hormaechei as plant growth-promoting bacteria for improvement in Lycopersicum esculentum. Curr. Microbiol. 2021, 78, 1208–1217. [Google Scholar] [CrossRef] [PubMed]
- Shurigin, V.; Egamberdieva, D.; Li, L.; Davranov, K.; Panosyan, H.; Birkeland, N.-K.; Wirth, S.; Bellingrath-Kimura, S.D. Endophytic bacteria associated with halophyte Seidlitzia rosmarinus Ehrenb. ex Boiss. from saline soil of Uzbekistan and their plant beneficial traits. J. Arid Land 2020, 12, 730–740. [Google Scholar] [CrossRef]
- Rasimus, S.; Mikkola, R.; Andersson, M.A.; Teplova, V.V.; Venediktova, N.; Ek-Kommonen, C.; Salkinoja-Salonen, M. Psychrotolerant Paenibacillus tundrae isolates from barley grains produce new cereulide-like depsipeptides (Paenilide and Homopaenilide) that are highly toxic to mammalian cells. Appl. Environ. Microbiol. 2012, 78, 3732–3743. [Google Scholar] [CrossRef]
- Vargas, P.; Bosmans, L.; Van Kerckhove, S.; Van Calenberge, B.; Raaijmakers, J.M.; Lievens, B.; Rediers, H. Optimizing biocontrol activity of Paenibacillus xylanexedens for management of hairy root disease in tomato grown in hydroponic greenhouses. Agronomy 2021, 11, 817. [Google Scholar] [CrossRef]
- Nelson, D.; Glawe, A.; Labeda, D.; Cann, I.; Mackie, R. Paenibacillus tundrae sp. nov. and Paenibacillus xylanexedens sp. nov., psychrotolerant, xylan-degrading bacteria from Alaskan tundra. Int. J. Syst. Evol. Microbiol. 2009, 59, 1708–1714. [Google Scholar] [CrossRef]
- Berg, G.; Martinez, J.L. Friends or foes: Can we make a distinction between beneficial and harmful strains of the Stenotrophomonas maltophilia complex? Front. Microbiol. 2015, 6, 241. [Google Scholar] [CrossRef]
- Cherif-Silini, H.; Thissera, B.; Bouket, A.C.; Saadaoui, N.; Silini, A.; Eshelli, M.; Alenezi, F.N.; Vallat, A.; Luptakova, L.; Yahiaoui, B.; et al. Durum wheat stress tolerance induced by endophyte Pantoea agglomerans with genes contributing to plant functions and secondary metabolite arsenal. Int. J. Mol. Sci. 2019, 20, 3989. [Google Scholar] [CrossRef]
- Rafique, E.; Mumtaz, M.Z.; Ullah, I.; Rehman, A.; Qureshi, K.A.; Kamran, M.; Rehman, M.U.; Jaremko, M.; Alenezi, M.A. Potential of mineral-solubilizing bacteria for physiology and growth promotion of Chenopodium quinoa Willd. Front Plant Sci 2022, 13, 1004833. [Google Scholar] [CrossRef]
- Araujo, R.; Dunlap, C.; Franco, C.M.M. Analogous wheat root rhizosphere microbial successions in field and greenhouse trials in the presence of biocontrol agents Paenibacillus peoriae SP9 and Streptomyces fulvissimus FU14. Mol. Plant Pathol. 2020, 21, 622–635. [Google Scholar] [CrossRef] [PubMed]
- Li, T.; Mann, R.; Kaur, J.; Spangenberg, G.; Sawbridge, T. Transcriptomics differentiate two novel bioactive strains of Paenibacillus sp. isolated from the perennial ryegrass seed microbiome. Sci. Rep. 2021, 11, 15545. [Google Scholar] [CrossRef] [PubMed]
- Khalaf, E.M.; Raizada, M.N. Draft genome sequences of seven strains of Paenibacillus spp. (Phylum Firmicutes) inhabiting the seeds of Cucumis melo L. (Cantaloupe) and exhibiting plant probiotic traits. Microbiol. Resour. Announc. 2020, 9, e00715-20. [Google Scholar] [CrossRef] [PubMed]
- Links, M.G.; Demeke, T.; Gräfenhan, T.; Hill, J.E.; Hemmingsen, S.M.; Dumonceaux, T.J. Simultaneous profiling of seed-associated bacteria and fungi reveals antagonistic interactions between microorganisms within a shared epiphytic microbiome on Triticum and Brassica seeds. New Phytol. 2014, 202, 542–553. [Google Scholar] [CrossRef]
- Beauregard, P.B.; Chai, Y.; Vlamakis, H.; Losick, R.; Kolter, R. Bacillus subtilis biofilm induction by plant polysaccharides. Proc. Natl. Acad. Sci. USA 2013, 110, E1621–E1630. [Google Scholar] [CrossRef]
- Pandit, A.; Adholeya, A.; Cahill, D.; Brau, L.; Kochar, M. Microbial biofilms in nature: Unlocking their potential for agricultural applications. J. Appl. Microbiol. 2020, 129, 199–211. [Google Scholar] [CrossRef]
- Karimi, E.; Aliasgharzad, N.; Esfandiari, E.; Hassanpouraghdam, M.B.; Neu, T.R.; Buscot, F.; Reitz, T.; Breitkreuz, C.; Tarkka, M.T. Biofilm forming rhizobacteria affect the physiological and biochemical responses of wheat to drought. AMB Express 2022, 12, 93. [Google Scholar] [CrossRef]
- Yin, W.; Wang, Y.; Liu, L.; He, J. Biofilms: The microbial “protective clothing” in extreme environments. Int. J. Mol. Sci. 2019, 20, 3423. [Google Scholar] [CrossRef]
- Kumar, M.; Mishra, S.; Dixit, V.; Kumar, M.; Agarwal, L.; Chauhan, P.S.; Nautiyal, C.S. Synergistic effect of Pseudomonas putida and Bacillus amyloliquefaciens ameliorates drought stress in chickpea (Cicer arietinum L.). Plant Signal. Behav. 2016, 11, e1071004. [Google Scholar] [CrossRef]
- Wang, D.C.; Jiang, C.H.; Zhang, L.N.; Chen, L.; Zhang, X.Y.; Guo, J.H. Biofilms positively contribute to Bacillus amyloliquefaciens 54-induced drought tolerance in tomato plants. Int. J. Mol. Sci. 2019, 20, 6271. [Google Scholar] [CrossRef]
- Susilowati, L.E.; Kusumo, B.H.; Arifin, Z. Screening of the drought tolerant phosphate solubilizing bacteria in dissolving P-inorganic. J. Phys. Conf. Ser. 2019, 1402, 055082. [Google Scholar] [CrossRef]
- Kang, S.-M.; Khan, M.-A.; Hamayun, M.; Kim, L.-R.; Kwon, E.-H.; Kang, Y.-S.; Kim, K.-Y.; Park, J.-J.; Lee, I.-J. Phosphate-solubilizing Enterobacter ludwigii AFFR02 and Bacillus megaterium Mj1212 rescues alfalfa’s growth under post-drought stress. Agriculture 2021, 11, 485. [Google Scholar] [CrossRef]
- Singh, P.; Chauhan, P.K.; Upadhyay, S.K.; Singh, R.K.; Dwivedi, P.; Wang, J.; Jain, D.; Jiang, M. Mechanistic insights and potential use of siderophores producing microbes in rhizosphere for mitigation of stress in plants grown in degraded land. Front. Microbiol. 2022, 13, 898979. [Google Scholar] [CrossRef] [PubMed]
- Breitkreuz, C.; Reitz, T.; Schulz, E.; Tarkka, M.T. Drought and plant community composition affect the metabolic and genotypic diversity of pseudomonas strains in grassland soils. Microorganisms 2021, 9, 1677. [Google Scholar] [CrossRef]
- Compant, S.; Mitter, B.; Colli-Mull, J.G.; Gangl, H.; Sessitsch, A. Endophytes of grapevine flowers, berries, and seeds: Identification of cultivable bacteria, comparison with other plant parts, and visualization of niches of colonization. Microb. Ecol. 2011, 62, 188–197. [Google Scholar] [CrossRef]
- Herms, C.H.; Hennessy, R.C.; Bak, F.; Dresbøll, D.B.; Nicolaisen, M.H. Back to our roots: Exploring the role of root morphology as a mediator of beneficial plant–microbe interactions. Environ. Microbiol. 2022, 24, 3264–3272. [Google Scholar] [CrossRef]
- Saberi Riseh, R.; Ebrahimi-Zarandi, M.; Gholizadeh Vazvani, M.; Skorik, Y.A. Reducing drought stress in plants by encapsulating plant growth-promoting bacteria with polysaccharides. Int. J. Mol. Sci. 2021, 22, 12979. [Google Scholar] [CrossRef]
- Blilou, I.; Xu, J.; Wildwater, M.; Willemsen, V.; Paponov, I.; Friml, J.; Heidstra, R.; Aida, M.; Palme, K.; Scheres, B. The PIN auxin efflux facilitator network controls growth and patterning in Arabidopsis roots. Nature 2005, 433, 39–44. [Google Scholar] [CrossRef]
- Camaille, M.; Fabre, N.; Clément, C.; Ait Barka, E. Advances in wheat physiology in response to drought and the role of plant growth promoting rhizobacteria to trigger drought tolerance. Microorganisms 2021, 9, 687. [Google Scholar] [CrossRef]
- Kasim, W.A.; Osman, M.E.H.; Omar, M.N.; Salama, S. Enhancement of drought tolerance in Triticum aestivum L. seedlings using Azospirillum brasilense NO40 and Stenotrophomonas maltophilia B11. Bull. Natl. Res. Cent. 2021, 45, 95. [Google Scholar] [CrossRef]

| Alfalfa (Medicago sativa) | Pitch Clover (Bituminaria bituminosa) | |||||||||
|---|---|---|---|---|---|---|---|---|---|---|
| Code | Location | Province (Country) | GPS | Altitude (mamsl) | # | Code | Location | Province (Country) | GPS | Altitude (mamsl) |
| Oeiras | Oeiras | Lisbon (PT) | 38°42′32.8″ N 9°16′02.3″ W | 60 | 1 | Oeiras | Oeiras | Lisbon (PT) | 38°42′32.8″ N 9°16′02.3″ W | 60 |
| G | Guadix | Granada (SP) | 37°19′03.1″ N 3°07′19.0″ W | 957 | 2 | G | Guadix | Granada (SP) | 37°19′03.1″ N 3°07′19.0″ W | 957 |
| A | Agost | Alacant (SP) | 38°26′15.6″ N 0°38′02.7″ W | 294 | 10 | B | Baza | Granada (SP) | 37°30′11.2″ N 2°47′08.1″ W | 890 |
| M | Medinaceli | Soria (SP) | 41°10′11.4″ N 2°25′16.9″ W | 1022 | 11 | HO | Huércal-Overa | Almería (SP) | 37°24′12.0″ N 1°56′16.4″ W | 278 |
| O | Orce | Granada (SP) | 37°44′01.8″ N 2°30′50.6″ W | 902 | 12 | CB | Carril-Busot | Alacant (SP) | 38°28′38.2″ N 0°25′18.7″ W | 295 |
| Be | Belchite | Zaragoza (SP) | 41°17′55.4″ N 0°44′37.2″ W | 440 | 13 | N | Níjar | Almería (SP) | 36°57′19.3″ N 2°12′21.8″ W | 282 |
| CM | Castejón de Monegros | Huesca (SP) | 41°37′12.0″ N 0°14′04.7″ W | 479 | 14 | L | Lorca | Murcia (SP) | 37°38′05.9″ N 1°44′24.9″ W | 356 |
| BR | Bárdenas Reales | Navarra (SP) | 42°10′34.0″ N 1°31′01.8″ W | 294 | 15 | V | Vera | Almería (SP) | 37°10′13.5″ N 1°56′43.5″ W | 127 |
| VR | Vélez-Rubio | Almería (SP) | 37°38′50.5″ N 2°05′12.3″ W | 845 | 9 | VR | Vélez-Rubio | Almería (SP) | 37°38′50.5″ N 2°05′12.3″ W | 845 |
| Climatic and Soil Conditions of Sampling Location | ||||||||||
|---|---|---|---|---|---|---|---|---|---|---|
| # | Location Code a | Average Precipitation (mm) b | Precipitation till July, 2022 (mm) c | Average Temperature in Summer (°C) d | Average Teperature in Summer 2022 (°C) d | General Geological Context e | Soil Type (FAO Classification) f | pH g | EC g,h (dS/m) | Water Content (%) g |
| 1 | Oeiras | 591 | 301 | 20.2 [23.4] | 24.2 [26.4] | Limestones | Calcic luvisol/calcisol | 8.04 | 0.15 | 12.92 |
| 2 | G | 290 | 184 | 25.5 [30.4] | 23.8 [28.5] | Sandstones/ conglomerates | Calcaric fluvisol | 9.20 | 0.67 | 0.73 |
| 3 | A | 345 | 245 | 24 [28.5] | 24.2 [32.3] | Conglomerates/ sandstones/ claystones/silstones | Haplic gypsisol | 9.27 | 5.54 | 0.70 |
| 4 | M | 489 | 136 | 19.8 [26.4] | 24.5 [30.9] | Conglomerates/ sandstones/silstones/ claystones | Cambic calcisol | 9.30 | 1.02 | 1.68 |
| 5 | O | 366 | 144 | 22.0 [28.6] | 22.3 [27.8] | Sandstones/ conglomerates | Cambic calcisol | 9.38 | 3.05 | 0.30 |
| 6 | Be | 354 | 130 | 22.5 [28.5] | 27.7 [34.9] | Sandstones/claystones/conglomerates | Haplic calsicol | 9.06 | 4.21 | 1.45 |
| 7 | CM | 341 | 56 | 23.4 [30.0] | 27.6 [35.1] | Conglomerates | Haplic gypsisol /calcisol | 9.29 | 5.62 | 1.46 |
| 8 | BR | 302 | 211 | 21.6 [28.2] | 26.3 [34.0] | Conglomerates/ sandstones/ silstones/claystones | Calcaric fluvisol/ Haplic calcisol | 8.46 | 6.43 | 1.25 |
| 9 | VR | 238 | 58 | 21.5 [27.8] | 26.5 [33.1] | Quartzite/ phyllites/ schists/limestones | Cambic calcisol | 9.18 | 4.87 | 0.25 |
| 10 | B | 335 | 195 | 22.7 [29.9] | 30.2 [31.3] | Marls/limestones | Calcaric fluvisol/ leptosol | 9.38 | 1.34 | 0.25 |
| 11 | HO | 244 | 36 | 20.9 [27.5] | 25.8 [33.5] | Marls/marly-limestones/ sandstones | Cambic cambisol | 9.26 | 3.22 | 0.62 |
| 12 | CB | 421 | 267 | 24.2 [32.3] | 24.2 [32.3] | Marls/limestone/ sandstones | Haplic gypsisol | 9.30 | 4.08 | 0.24 |
| 13 | N | 223 | 77 | 24.0 [28.7] | 27.2 [29.9] | Marls/ sandstones | Haplic calcisol | 9.69 | 1.78 | 0.40 |
| 14 | L | 280 | 89 | 27.9 [35.6] | 23.8 [29.4] | Conglomerates/ sandstones | Eutric cambisol/ Calcaric fluvisol | 8.77 | 2.67 | 0.37 |
| 15 | V | 278 | 68 | 24.5 [28] | 25.9 [29.3] | Marls | Cambic calcisol | 9.39 | 1.24 | 0.50 |
| # | Isolate Code | Scientific Name | Plant | Sampling Location | Skill Screening | ||||||
|---|---|---|---|---|---|---|---|---|---|---|---|
| Bfm. | Aux. | ACCd | P.sol. | Sdr. | Spr. | Xer. | |||||
| 1 | MS A-A | Paenibacillus polymyxa | M. sativa | Agost | - | + | - | - | - | ++ | - |
| 2 | MS A-B | Unidentified | M. sativa | Agost | ++ | + | + | - | - | +++ | + |
| 3 | BB CB-A | Unidentified | B. bituminosa | Carril-Busot | + | ++ | + | + | - | +++ | - |
| 4 | MS GX-A | Endophytic bacterium | M. sativa | Guadix | ++ | + | ++ | + | - | +++ | + |
| 5 | BB CB-C | Bacillus nealsonii | B. bituminosa | Carril-Busot | +++ | + | + | - | + | +++ | + |
| 6 | BB GX-A | Stenotrophomonas maltophilia | B. bituminosa | Guadix | +++ | + | ++ | + | + | - | + |
| 7 | BB GX-B | Priestia megaterium | B. bituminosa | Guadix | + | + | ++ | + | - | +++ | + |
| 8 | BB GX-C | Unidentified | B. bituminosa | Guadix | + | + | - | - | + | + | + |
| 9 | BB L-B | Stenotrophomonas maltophilia | B. bituminosa | Lorca | ++ | + | + | - | + | - | + |
| 10 | BB L-C | Paenibacillus peoriae | B. bituminosa | Lorca | ++ | + | + | + | + | ++ | + |
| 11 | MS GX-C | Stenotrophomonas maltophilia | M. sativa | Guadix | +++ | ++ | + | - | - | - | + |
| 12 | MS GX-D | Stenotrophomonas maltophilia | M. sativa | Guadix | ++ | ++ | ++ | + | - | - | + |
| 13 | BB Ve-A | Enterobacter ludwigii | B. bituminosa | Vera | - | + | ++ | - | - | - | + |
| 14 | BB Ve-B | Stenotrophomonas maltophilia | B. bituminosa | Vera | ++ | + | + | - | - | - | + |
| 15 | BB Ve-C | Unidentified | B. bituminosa | Vera | + | ++ | + | + | - | - | + |
| 16 | BB L-A | Enterobacter hormaechei | B. bituminosa | Lorca | + | ++ | + | + | - | - | + |
| 17 | BB CB-B | Stenotrophomonas maltophilia | B. bituminosa | Carril-Busot | ++ | ++ | + | + | - | - | + |
| 18 | MS GX-B | Pantoea agglomerans | M. sativa | Guadix | + | ++ | ++ | - | + | - | + |
| 19 | MS CM2-A | Paenibacillus polymyxa | M. sativa | C. de Monegros | + | ++ | ++ | + | - | ++ | + |
| 20 | MS CM2-B | Stenotrophomonas maltophilia | M. sativa | C. de Monegros | ++ | + | + | - | + | - | + |
| 21 | MS CM2-C | Stenotrophomonas maltophilia | M. sativa | C. de Monegros | ++ | + | ++ | + | + | - | + |
| 22 | MS BE1-A | Atlantibacter hermannii | M. sativa | Belchite | + | + | ++ | - | + | - | + |
| 23 | MS BE1-B | Paenibacillus polymyxa | M. sativa | Belchite | ++ | ++ | ++ | - | + | ++ | + |
| 24 | MS BE1-C | Stenotrophomonas maltophilia | M. sativa | Belchite | ++ | + | ++ | - | + | - | + |
| 25 | MS BR1-A | Paenibacillus polymyxa | M. sativa | Bárdenas Reales | ++ | ++ | ++ | - | + | +++ | + |
| 26 | MS BR1-B | Paenibacillus polymyxa | M. sativa | Bárdenas Reales | +++ | ++ | ++ | - | - | ++ | + |
| 27 | MS BR1-C | Stenotrophomonas maltophilia | M. sativa | Bárdenas Reales | +++ | ++ | ++ | - | + | - | - |
| 28 | MS O1-A | Paenibacillus polymyxa | M. sativa | Orce | - | +++ | ++ | - | + | ++ | - |
| 29 | MS O1-B | Paenibacillus polymyxa | M. sativa | Orce | ++ | ++ | +++ | - | + | ++ | - |
| 30 | MS M1-A | Bacillus cereus | M. sativa | Medinaceli | ++ | + | +++ | + | + | +++ | + |
| 31 | MS M1-B | Stenotrophomonas maltophilia | M. sativa | Medinaceli | ++ | + | ++ | + | + | - | + |
| 32 | MS M1-C | Paenibacillus xylanexedens | M. sativa | Medinaceli | ++ | + | +++ | + | + | + | + |
| 33 | MS M1-D | Enterobacter hormaechei | M. sativa | Medinaceli | ++ | ++ | + | + | + | - | + |
| 34 | BB B2-A | Paenibacillus amylolyticus | B. bituminosa | Baza | ++ | ++ | ++ | - | + | ++ | + |
| 35 | BB B2-B | Pantoea agglomerans | B. bituminosa | Baza | ++ | + | + | - | + | + | + |
| 36 | BB B2-C | Enterobacter hormaechei | B. bituminosa | Baza | +++ | + | + | + | + | - | + |
| 37 | BB B2-D | Stenotrophomonas maltophilia | B. bituminosa | Baza | ++ | + | + | - | + | - | + |
| 38 | MS VR1-A | Stenotrophomonas maltophilia | M. sativa | Vélez-Rubio | - | +++ | + | - | + | ++ | - |
| 39 | MS VR1-B | Stenotrophomonas maltophilia | M. sativa | Vélez-Rubio | ++ | + | + | - | + | - | + |
| 40 | MS VR1-C | Kosakonia cowanii | M. sativa | Vélez-Rubio | + | + | ++ | - | - | - | + |
| 41 | MS Oeiras | Paenibacillus polymyxa | M. sativa | Oeiras | - | ++ | ++ | - | + | +++ | + |
| 42 | BB Ni-A | Stenotrophomonas maltophilia | B. bituminosa | Níjar | ++ | + | ++ | + | + | - | + |
| 43 | BB Ni-B | Paenibacillus tundrae | B. bituminosa | Níjar | + | + | ++ | - | + | +++ | + |
| 44 | BB Ni-C | Erwinia sp. | B. bituminosa | Níjar | ++ | ++ | + | + | + | - | + |
| 45 | BB Oeiras A | Paenibacillus pabuli | B. bituminosa | Oeiras | +++ | +++ | ++ | + | - | +++ | + |
| 46 | BB VR-A | Stenotrophomonas maltophilia | B. bituminosa | Vélez-Rubio | + | ++ | + | - | + | - | + |
| 47 | BB VR-B | Stenotrophomonas maltophilia | B. bituminosa | Vélez-Rubio | ++ | ++ | + | + | + | - | + |
| 48 | BB VR-C | Stenotrophomonas maltophilia | B. bituminosa | Vélez-Rubio | ++ | ++ | ++ | + | + | - | - |
| 49 | BB Oeiras B | Stenotrophomonas maltophilia | B. bituminosa | Oeiras | - | +++ | + | - | + | - | - |
| 50 | BB HO A | Unidentified | B. bituminosa | Huércal-Overa | + | + | - | + | - | - | - |
| 51 | BB HO B | Unidentified | B. bituminosa | Huércal-Overa | + | + | + | - | + | - | - |
Publisher’s Note: MDPI stays neutral with regard to jurisdictional claims in published maps and institutional affiliations. |
© 2022 by the authors. Licensee MDPI, Basel, Switzerland. This article is an open access article distributed under the terms and conditions of the Creative Commons Attribution (CC BY) license (https://creativecommons.org/licenses/by/4.0/).
Share and Cite
Niza-Costa, M.; Rodríguez-dos Santos, A.S.; Rebelo-Romão, I.; Ferrer, M.V.; Sequero López, C.; Vílchez, J.I. Geographically Disperse, Culturable Seed-Associated Microbiota in Forage Plants of Alfalfa (Medicago sativa L.) and Pitch Clover (Bituminaria bituminosa L.): Characterization of Beneficial Inherited Strains as Plant Stress-Tolerance Enhancers. Biology 2022, 11, 1838. https://doi.org/10.3390/biology11121838
Niza-Costa M, Rodríguez-dos Santos AS, Rebelo-Romão I, Ferrer MV, Sequero López C, Vílchez JI. Geographically Disperse, Culturable Seed-Associated Microbiota in Forage Plants of Alfalfa (Medicago sativa L.) and Pitch Clover (Bituminaria bituminosa L.): Characterization of Beneficial Inherited Strains as Plant Stress-Tolerance Enhancers. Biology. 2022; 11(12):1838. https://doi.org/10.3390/biology11121838
Chicago/Turabian StyleNiza-Costa, Marla, Ana Sofía Rodríguez-dos Santos, Inês Rebelo-Romão, María Victoria Ferrer, Cristina Sequero López, and Juan Ignacio Vílchez. 2022. "Geographically Disperse, Culturable Seed-Associated Microbiota in Forage Plants of Alfalfa (Medicago sativa L.) and Pitch Clover (Bituminaria bituminosa L.): Characterization of Beneficial Inherited Strains as Plant Stress-Tolerance Enhancers" Biology 11, no. 12: 1838. https://doi.org/10.3390/biology11121838
APA StyleNiza-Costa, M., Rodríguez-dos Santos, A. S., Rebelo-Romão, I., Ferrer, M. V., Sequero López, C., & Vílchez, J. I. (2022). Geographically Disperse, Culturable Seed-Associated Microbiota in Forage Plants of Alfalfa (Medicago sativa L.) and Pitch Clover (Bituminaria bituminosa L.): Characterization of Beneficial Inherited Strains as Plant Stress-Tolerance Enhancers. Biology, 11(12), 1838. https://doi.org/10.3390/biology11121838

